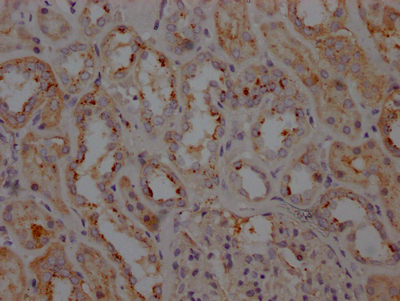

LRRK2 Recombinant Monoclonal Antibody
-
中文名稱:LRRK2重組抗體
-
貨號:CSB-RA797150A0HU
-
規格:¥1320
-
圖片:
-
IHC image of CSB-RA797150A0HU diluted at 1:100 and staining in paraffin-embedded human kidney tissue performed on a Leica BondTM system. After dewaxing and hydration, antigen retrieval was mediated by high pressure in a citrate buffer (pH 6.0). Section was blocked with 10% normal goat serum 30min at RT. Then primary antibody (1% BSA) was incubated at 4℃ overnight. The primary is detected by a Goat anti-rabbit IgG polymer labeled by HRP and visualized using 0.05% DAB.
-
-
其他:
產品詳情
-
產品描述:CSB-RA797150A0HU LRRK2重組單克隆抗體是經ELISA和免疫組化(IHC)嚴格驗證的高特異性試劑,適用于神經科學研究領域。該抗體靶向的LRRK2(富含亮氨酸重復激酶2)是一種在帕金森病發病機制中起關鍵作用的絲氨酸/蘇氨酸激酶,尤其與家族性帕金森病相關的基因突變密切相關。LRRK2通過調控囊泡運輸、自噬及神經炎癥等細胞過程參與多巴胺能神經元的功能維持。實驗數據顯示,該抗體在IHC應用中表現出優異的組織穿透性和抗原識別能力,推薦使用1:50-1:200稀釋比例,可在腦組織切片中清晰呈現LRRK2的亞細胞定位及表達水平。其高靈敏度和低交叉反應性特點,使其成為研究神經退行性疾病分子機制、構建帕金森病體外模型的理想工具,適用于神經信號通路解析、疾病相關蛋白互作研究及藥物靶點篩選等科研場景,為探索LRRK2在病理生理過程中的功能提供可靠實驗支持。
-
Uniprot No.:
-
基因名:
-
別名:Leucine-rich repeat serine/threonine-protein kinase 2 (EC 2.7.11.1) (Dardarin), LRRK2, PARK8
-
反應種屬:Human
-
免疫原:A synthesized peptide derived from human LRRK2
-
免疫原種屬:Homo sapiens (Human)
-
標記方式:Non-conjugated
-
克隆類型:Monoclonal
-
抗體亞型:Rabbit IgG
-
純化方式:Affinity-chromatography
-
克隆號:4E9
-
濃度:It differs from different batches. Please contact us to confirm it.
-
保存緩沖液:Rabbit IgG in 10mM phosphate buffered saline , pH 7.4, 150mM sodium chloride, 0.05% BSA, 0.02% sodium azide and 50% glycerol.
-
產品提供形式:Liquid
-
應用范圍:ELISA, IHC
-
推薦稀釋比:
Application Recommended Dilution IHC 1:50-1:200 -
Protocols:
-
儲存條件:Upon receipt, store at -20°C or -80°C. Avoid repeated freeze.
-
貨期:Basically, we can dispatch the products out in 1-3 working days after receiving your orders. Delivery time maybe differs from different purchasing way or location, please kindly consult your local distributors for specific delivery time.
-
用途:For Research Use Only. Not for use in diagnostic or therapeutic procedures.
相關產品
靶點詳情
-
功能:Serine/threonine-protein kinase which phosphorylates a broad range of proteins involved in multiple processes such as neuronal plasticity, autophagy, and vesicle trafficking. Is a key regulator of RAB GTPases by regulating the GTP/GDP exchange and interaction partners of RABs through phosphorylation. Phosphorylates RAB3A, RAB3B, RAB3C, RAB3D, RAB5A, RAB5B, RAB5C, RAB8A, RAB8B, RAB10, RAB12, RAB35, and RAB43. Regulates the RAB3IP-catalyzed GDP/GTP exchange for RAB8A through the phosphorylation of 'Thr-72' on RAB8A. Inhibits the interaction between RAB8A and GDI1 and/or GDI2 by phosphorylating 'Thr-72' on RAB8A. Regulates primary ciliogenesis through phosphorylation of RAB8A and RAB10, which promotes SHH signaling in the brain. Together with RAB29, plays a role in the retrograde trafficking pathway for recycling proteins, such as mannose-6-phosphate receptor (M6PR), between lysosomes and the Golgi apparatus in a retromer-dependent manner. Regulates neuronal process morphology in the intact central nervous system (CNS). Plays a role in synaptic vesicle trafficking. Plays an important role in recruiting SEC16A to endoplasmic reticulum exit sites (ERES) and in regulating ER to Golgi vesicle-mediated transport and ERES organization. Positively regulates autophagy through a calcium-dependent activation of the CaMKK/AMPK signaling pathway. The process involves activation of nicotinic acid adenine dinucleotide phosphate (NAADP) receptors, increase in lysosomal pH, and calcium release from lysosomes. Phosphorylates PRDX3. By phosphorylating APP on 'Thr-743', which promotes the production and the nuclear translocation of the APP intracellular domain (AICD), regulates dopaminergic neuron apoptosis. Independent of its kinase activity, inhibits the proteosomal degradation of MAPT, thus promoting MAPT oligomerization and secretion. In addition, has GTPase activity via its Roc domain which regulates LRRK2 kinase activity.
-
基因功能參考文獻:
- G2019S carriers had a more benign phenotype than non-carriers and LRRK2 gene dosage does not influence the severity of Parkinson's disease PMID: 29989150
- The data of this study and the existing results strongly suggest that the autonomic features of manifesting LRRK2 mutation carriers are generally indistinguishable from those of sporadic Parkinson's disease. PMID: 28483388
- that the hemipterous pathway plays an important role in Lrrk2-linked Parkinsonism in flies PMID: 29268033
- Our findings reveal a new function of LRRK2 mediated by Rab8a phosphorylation and related to various centrosomal defects. PMID: 29357897
- This review summarizes the cellular function and pathophysiology of LRRK2 ROCO domain mutations in PD and the perspective of therapeutic approaches. PMID: 29903014
- Aging brain is more susceptible to LRRK2-associated pathology, and in this model, glial LRRK2 expression significantly contributed to neuroinflammation, ultimately causing neurodegeneration such as Parkinson's disease. PMID: 29550548
- LRRK2 R1398H or N551K variants do not appear to modulate the risk of Alzheimer's disease. PMID: 29241968
- Mutant LRRK2 disrupts synaptic vesicle endocytosis, leading to altered dopamine metabolism and dopamine-mediated toxic effects in patient-derived dopaminergic neurons. PMID: 29735704
- Rab8a is phosphorylated by LRRK2. PMID: 29482628
- Interrogating Parkinson's disease LRRK2 kinase pathway activity by assessing Rab10 phosphorylation in human neutrophils has been reported. PMID: 29127255
- In vivo activity of the LRRK2 Parkinson's disease kinase has been reported. PMID: 29127256
- Studied leucine rich repeat kinase 2 (LRRK2)-WAS protein family member 2 (WAVE2) pathway in modulation of phagocytosis in leukocytes, as well as its possible role for altered immune function in Parkinson's Disease. PMID: 29760073
- The LRRK2 mutation Gly2019Ser is the most common genetic cause of Parkinson's disease worldwide. PMID: 27751534
- we found that patients with Parkinson's disease who were carriers of the G2385R variant of the LRRK2 gene were more prone to fatigue than non-carriers PMID: 28941828
- These data indicate that mitochondrial deficits in the context of LRRK2 G2019S are not a global phenomenon and point to distinct sirtuin and bioenergetic deficiencies intrinsic to dopaminergic neurons, which may underlie dopaminergic neuron loss in Parkinson's disease. PMID: 29129681
- The G2019S-LRRK2 mutation upregulates LRRK2-kinase activity-dependent autophosphorylation at Ser1292 in exosomes captured from peripheral and brain-derived exosomes. LRRK2 protein in brain exosomes may be much more active than in the periphery in most subjects PMID: 29166931
- phosphorylation of LRRK2 following inhibitor treatment shows target engagement in peripheral mononuclear cells from Parkinson's disease patients PMID: 27503089
- Data indicate the generation of an Induced pluripotent stem cells (iPSCs)-based model of idiopathic Parkinson's disease (iPD) with or without RS1491923, which is a common risk variant in the leucine rich repeat kinase 2 (LRRK2) locus. PMID: 29513666
- These results implicate LRRK2 in primary ciliogenesis and suggest that Rab-mediated protein transport and/or signaling defects at cilia may contribute to LRRK2-dependent pathologies. PMID: 29125462
- Comparative analysis of motor and non-motor features in LRRK2 and GBA mutation carriers and non-carriers conducted in a cohort from Brazil, a country with a highly miscegenated population. Similarly to other studies, our results suggest that mutations in GBA and LRRK2 influence the clinical signs of the Parkinson's disease, with significant implications for handling of specific patient groups. PMID: 28991672
- that LRRK2 regulates the balance between WNT/beta-catenin and WNT/PCP signaling PMID: 28697798
- Study describes a distinctive genomic signature of neural and intestinal organoids from familial Parkinson's disease patient-derived induced pluripotent stem cells with leucine-rich repeat kinase 2 mutatiin (LK2GS) . Study provides the first evidence that LK2GS mutation also causes significant changes in gene expression in the intestinal cells. PMID: 28235153
- human induced pluripotent stem cells (hiPSCs) reprogrammed from skin fibroblasts of Parkinson's disease patients suffering from the LRKK2 G2019S mutation. PMID: 27640816
- S129P-alphaS plays a role in the maintenance or formation of long neurites. PMID: 28826027
- Nrf2 sequestered misfolded diffuse LRRK2 into more insoluble and homogeneous inclusion bodies. PMID: 28028237
- R1628P variant of LRRK2 has a significant association with the risk of PD. PMID: 27812003
- Mild cognitive impairment may appear earlier than motor dysfunctions in LRRK2-G2019S mutation carriers. PMID: 28487191
- Authors found that HOTAIR was up-regulated in midbrain tissue of MTPT induced PD mice and in SH-SY5Y cells exposed to MPP+. With the presence of HOTAIR overexpression in SH-SY5Y cells, the expression of LRRK2 was increased compared with that in the control. PMID: 28445933
- Findings support the hypothesis that LRRK2 G2019S-induced mtDNA damage is LRRK2 kinase activity dependent, uncovering a novel pathological role for this kinase. PMID: 28973664
- Author demonstrated that LRRK2 increases the expression of p53 and p21 by increasing the Mdm2 phosphorylation in response to DNA damage. Loss-of-function in LRRK2 has the opposite effect to that of LRRK2. PMID: 28973420
- report that LRRK2(G2019S) mutation carriers with Parkinson's disease exhibit a high concentration of mitochondrial DNA in cerebrospinal fluid PMID: 27260835
- The results of this study suggest that mutations on specific genes (PARK2 and LRRK2) compromising basal ganglia functioning may be subtly related to language-processing mechanisms. PMID: 28205494
- Mutations in leucine-rich repeat kinase 2 (LRRK2) are the major genetic cause of autosomal-dominantly inherited Parkinson's disease. LRRK2 is implicated in the regulation of intracellular trafficking, neurite outgrowth and PD risk in connection with Rab7L1, a putative interactor of LRRK2. The modulation of Ser72 phosphorylation in Rab7L1 resulted in an alteration of the trans-Golgi network. PMID: 29223392
- This study identified five microRNAs that play a role in the etiology of Parkinson's disease likely by modifying expression of LRRK2 and additional genes required for normal cellular function. PMID: 27717584
- Thus study shown LRRK2 does not appear to play a major role in dementia with Lewy bodies. PMID: 27521182
- LRRK2-induced apoptosis was suppressed by ASK1 inhibition in neuronal stem cells derived from patients with Parkinson's disease (PD). These results clearly indicate that LRRK2 acts as an upstream kinase in the ASK1 pathway and plays an important role in the pathogenesis of PD PMID: 28888991
- The results of this study revealed clinical heterogeneity of the LRRK2 p.I2012T substitution, and demonstrated the use of targeted NGS for genetic diagnosis in multiplex families with PD or mixed neurodegenerative disorders. PMID: 27628070
- Parkinson's disease is associated with mutations in LRRK2 gene in Ashkenazi Jews. PMID: 27449028
- Data elucidate the mechanism underlying the increased microtubules association of select pathogenic LRRK2 mutants or of pharmacologically kinase-inhibited LRRK2, with implications for downstream microtubule-mediated transport events. PMID: 28453723
- Inflammation seems to be associated with the presence of a specific clinical subtype in PDLRRK2 that is characterized by a broad and more severely affected spectrum of motor and non-motor symptoms PMID: 28102045
- R1628P polymorphism of the LRRK2 gene contributes to Parkinson's disease susceptibility in Asian, especially Chinese, populations.[meta-analysis] PMID: 27384489
- In contrast to PD, common LRRK2 variants do not appear to play a major role in determining PSP and corticobasal degeneration risk. PMID: 27709685
- G2385R and G2019S Parkinson's disease appear to have motor differences PMID: 27091104
- LRRK2 regulates intracellular Tau levels, contributing to the progression of the pathology caused by the LRRK2-mediated proteasome impairment. PMID: 26014385
- The G2019S mutation is associated with increased asymmetry and variability among nonmanifesting participants and patients with PD. PMID: 27430880
- Peripheral inflammation is higher in a percentage of Parkinson subjects carrying the LRRK2 G2019S mutation. PMID: 26917005
- The CSF protein profile differs in LRRK2-associated PD and idiopathic PD, suggesting that pathophysiological mechanisms different from IPD underlie LRRK2-associated PD. PMID: 27041685
- Asymptomatic LRRK2 mutation carriers showed functional connectivity changes in striatocortical and nigrocortical circuits compared with noncarriers. PMID: 27653520
- LRRK2 transgenic mice develop motor impairment and selective activation of CB2 receptor partially reversed the deficits. PMID: 27063942
- Study found elevated LRRK2 levels in CD14++ and CD16+ monocyte subsets of Parkinson's disease patients, but not in patients' B-cells; and a dysregulation of monocyte subpopulations was detected in LRRK2 overexpressing mice. PMID: 27884177
顯示更多
收起更多
-
相關疾病:Parkinson disease 8 (PARK8)
-
亞細胞定位:Cytoplasmic vesicle. Perikaryon. Golgi apparatus membrane; Peripheral membrane protein. Cell projection, axon. Cell projection, dendrite. Endoplasmic reticulum membrane; Peripheral membrane protein. Cytoplasmic vesicle, secretory vesicle, synaptic vesicle membrane. Endosome. Lysosome. Mitochondrion outer membrane; Peripheral membrane protein.
-
蛋白家族:Protein kinase superfamily, TKL Ser/Thr protein kinase family
-
組織特異性:Expressed in pyramidal neurons in all cortical laminae of the visual cortex, in neurons of the substantia nigra pars compacta and caudate putamen (at protein level). Expressed in neutrophils (at protein level). Expressed in the brain. Expressed throughout
-
數據庫鏈接:
Most popular with customers
-
-
YWHAB Recombinant Monoclonal Antibody
Applications: ELISA, WB, IHC, IF, FC
Species Reactivity: Human, Mouse, Rat
-
Phospho-YAP1 (S127) Recombinant Monoclonal Antibody
Applications: ELISA, WB, IHC
Species Reactivity: Human
-
-
-
-
-